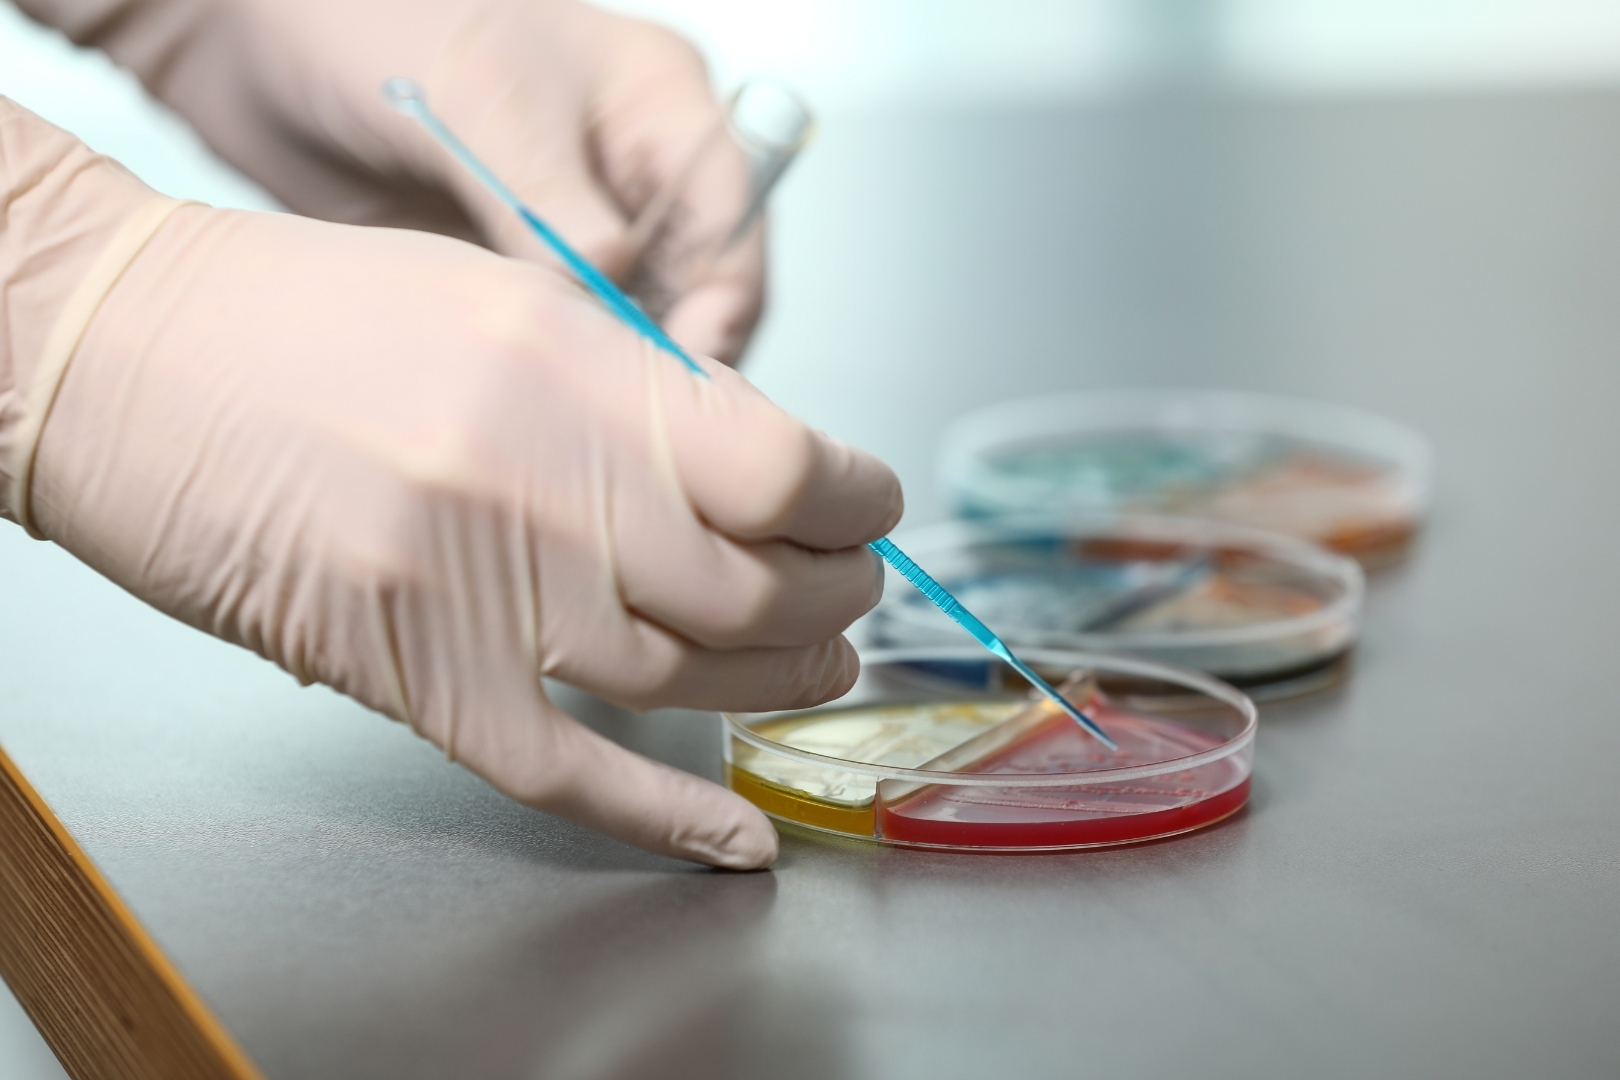

Willkommen in der Spezialpraxis Urologie!
"Gesundheit ist nicht alles, aber ohne Gesundheit ist alles nichts." - Arthur Schopenhauer
Wir bieten u.a.
- Früherkennung
- Uro-Onkologie & Medikamentöse Tumortherapie
- Zweitmeinung

Aktuelles
Aktuelle Informationen zu Themen wie neuen Angeboten, geänderten Sprechstundenzeiten, etc.
Am 9.4. findet Nachmittags keine Sprechstunde statt.
Wir sind als Terminpraxis organisiert. Unsere telefonische Erreichbarkeit wird durch unseren digitalen Assistenten unterstützt - geben Sie zur effektiven Bearbeitung bitte Ihren Namen, Geburtsdatum und eine Mobil-Nr. an - Dieser ist auch auf unserer Homepage nutzbar!
Bitte vereinbaren Sie auch zur Blutabnahme einen Termin.
Nutzen Sie unsere komfortable Onlineterminierung über Doctolib.
Ihr Praxisteam Berlin, den 8.4.2026

Früherkennung für Ihre Gesundheit an erster Stelle
Unsere moderne Praxis bietet Ihnen umfassende urologische Dienstleistungen zur Früherkennung. Wir unterstützen Sie bei Tests und Vorsorgemaßnahmen, die Ihre Gesundheit unterstützen. Vertrauen Sie auf unsere Expertise für Ihr Wohlbefinden.
Uro-Onkologische Versorgung
Wir bieten Ihnen eine umfassende onkologische Versorgung mit der Möglichkeit einer Zweitmeinung. Für weitere Informationen besuchen Sie die hier verlinkte Seite.



Zweitmeinung in der Urologie
Eine zweite Meinung hilft, Diagnosen und Therapien besser zu verstehen und fundierte Entscheidungen zu treffen. Wir prüfen Ihre Befunde, klären Alternativen und beraten Sie unabhängig – für Ihre Gesundheit und Ihr Wohlbefinden.
Organisatorisches
Allgemeine Informationen zu Parkplätzen, Terminbuchung & mehr
Wir sind als Terminpraxis organisiert.
Unsere telefonische Erreichbarkeit wird durch unseren digitalen Assistenten unterstützt - geben Sie zur effektiven Bearbeitung bitte Ihren Namen, Geburtsdatum und eine Mobil-Nr. an - Dieser ist auch auf unserer Homepage nutzbar!
Bitte vereinbaren Sie auch zur Blutabnahme einen Termin.
Nutzen Sie unsere komfortable Onlineterminierung über Doctolib.
Die Parkplätze vor dem Haus sowie eine Tiefgarage mit Direktzugang zu den Aufzügen erleichtern Ihnen den Praxisbesuch
Patientenstimmen
Was unsere Patienten über uns sagen
Unsere Praxis
Ein kleiner Einblick in unsere Räume & Alltag.
Vereinbaren Sie jetzt Ihren Termin
Buchen Sie einfach via Doctolib einen Termin